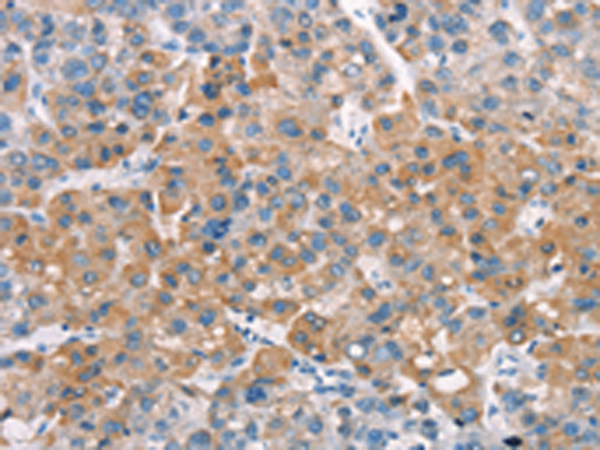
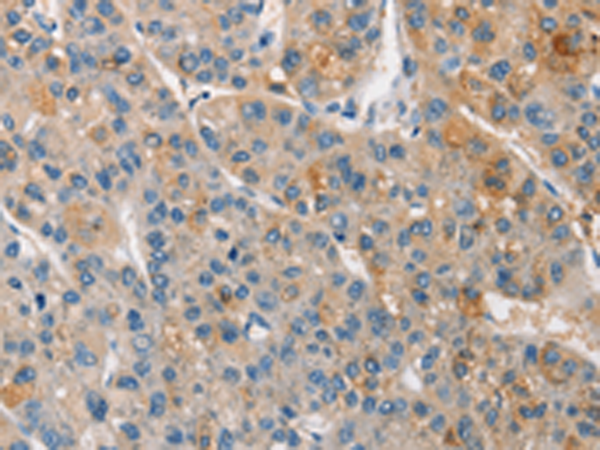
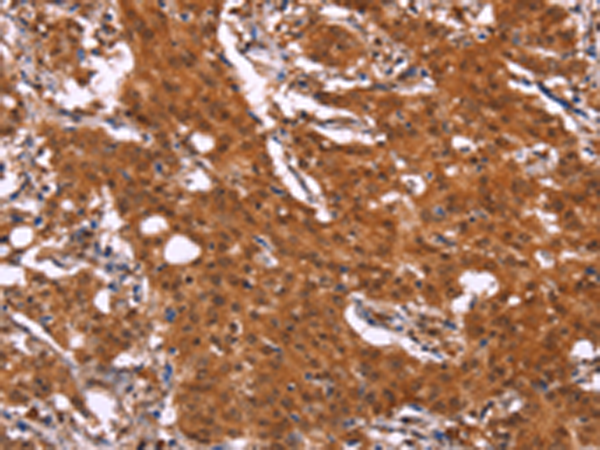

-
分类: 科研抗体货号: P11195别名: APO-CIV; APOC-IV应用: IHC反应种属: Human
-
分类: 科研抗体货号: P11213别名: KPM应用: IHC反应种属: Human, Mouse
-
分类: 科研抗体货号: P11210别名:应用: IHC反应种属: Human, Mouse
-
分类: 科研抗体货号: P11208别名: CAE; CAE1; CX50; CZP1; MP70; CTRCT1应用: IHC反应种属: Human, Mouse, Rat
-
分类: 科研抗体货号: P11194别名: RAP3; APOAV应用: IHC反应种属: Human
-
分类: 科研抗体货号: P11207别名: EKV; CX30.3应用: WB,IHC反应种属: Human, Mouse
-
分类: 科研抗体货号: P11193别名: AIBP; PEBEL; YJEFN1; APOA1BP应用: IHC反应种属: Human, Mouse, Rat
-
分类: 科研抗体货号: P11206别名: CD289应用: IHC反应种属: Human
-
分类: 科研抗体货号: P11192别名: BSCv; C20orf3应用: WB,IHC反应种属: Human
-
分类: 科研抗体货号: P11205别名: CL1; DCLK; CLICK1; DCDC3A; DCAMKL1应用: IHC反应种属: Human, Mouse

鄂公网安备42018502007531号
鄂公网安备42018502007531号

